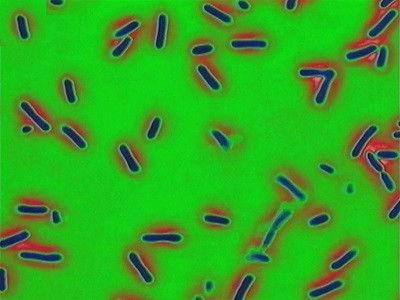
Forensic Files Season 7 Episode 8 - Bio-Attack

Episode Rankings
- #1 Fan Favorite
The 20 BEST Episodes of Forensic Files
READ

Every episode of Forensic Files Season 7 ranked from best to worst. Discover the Best Episodes of Forensic Files Season 7!
Real crimes, disease outbreaks and accidents around the world are solved by experts using scientific laboratory analysis which helps them find previously undetectable evidence. Brilliant scientific work helps convict the guilty and free the innocent.
"The Cheater" is the best rated episode of "Forensic Files" season 7. It scored /10 based on 0 votes. Directed by Unknown and written by Unknown, it aired on 1/1/2002. This episode is rated 0.0 points higher than the second-best, "Forever Hold Your Peace".